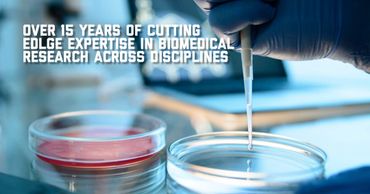

World Pharmaceutical Technology
COVID-19 Medical Supplies
Natural Health Products
Cancer Research and Development
World Pharmaceutical Technology
COVID-19 Medical Supplies
Natural Health Products
Cancer Research and Development
COVID-19 Medical Supplies
Natural Health Products
Cancer Research and Development
COVID-19 Medical Supplies
Natural Health Products
Cancer Research and Development

World Pharmaceutical Technology LLC respects your right to privacy while using our websites. We take the protection of personal data very seriously and will only collect, process, and use any personal data that you provide in this contact form in accordance with our data privacy policy. Please feel free to reach out to us directly at: info@worldpharmatech.com
WORLD PHARMACEUTICAL TECHNOLOGY LLC
17870 CASTLETON ST. SUITE 215 CITY OF INDUSTRY, CA 91748 UNITED STATES
Copyright © 2018 - 2023 World Pharmatech - All Rights Reserved.